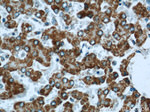
FMO5 Antibody in Immunohistochemistry (Paraffin) (IHC (P))

Search
Proteintech
FMO5 Polyclonal Antibody
{{$productOrderCtrl.translations['antibody.pdp.commerceCard.promotion.promotions']}}
{{$productOrderCtrl.translations['antibody.pdp.commerceCard.promotion.viewpromo']}}
{{$productOrderCtrl.translations['antibody.pdp.commerceCard.promotion.promocode']}}: {{promo.promoCode}} {{promo.promoTitle}} {{promo.promoDescription}}. {{$productOrderCtrl.translations['antibody.pdp.commerceCard.promotion.learnmore']}}
产品信息
16864-1-AP
种属反应
已发表种属
宿主/亚型
分类
类型
抗原
偶联物
形式
浓度
规格
纯化类型
保存液
内含物
保存条件
运输条件
靶标信息
Metabolic N-oxidation of the diet-derived amino-trimethylamine (TMA) is mediated by flavin-containing monooxygenase and is subject to an inherited FMO3 polymorphism in man resulting in a small subpopulation with reduced TMA N-oxidation capacity resulting in fish odor syndrome Trimethylaminuria. Three forms of the enzyme, FMO1 found in fetal liver, FMO2 found in adult liver, and FMO3 are encoded by genes clustered in the 1q23-q25 region. Flavin-containing monooxygenases are NADPH-dependent flavoenzymes that catalyzes the oxidation of soft nucleophilic heteroatom centers in drugs, pesticides, and xenobiotics. Alternative splicing results in multiple transcript variants.
仅用于科研。不用于诊断过程。未经明确授权不得转售。
生物信息学
蛋白别名: Baeyer-Villiger monooxygenase 1; Dimethylaniline monooxygenase [N-oxide-forming] 5; Dimethylaniline oxidase 5; flavin containing monooxygenase 5; Flavin-containing monooxygenase 5; FMO 5; hBVMO1; Hepatic flavin-containing monooxygenase 5; NADPH oxidase; NAPDH oxidase; unnamed protein product
基因别名: 5033418D19Rik; AI195026; FMO5; hBVMO1
UniProt ID: (Human) P49326, (Mouse) P97872
Entrez Gene ID: (Human) 2330, (Mouse) 14263